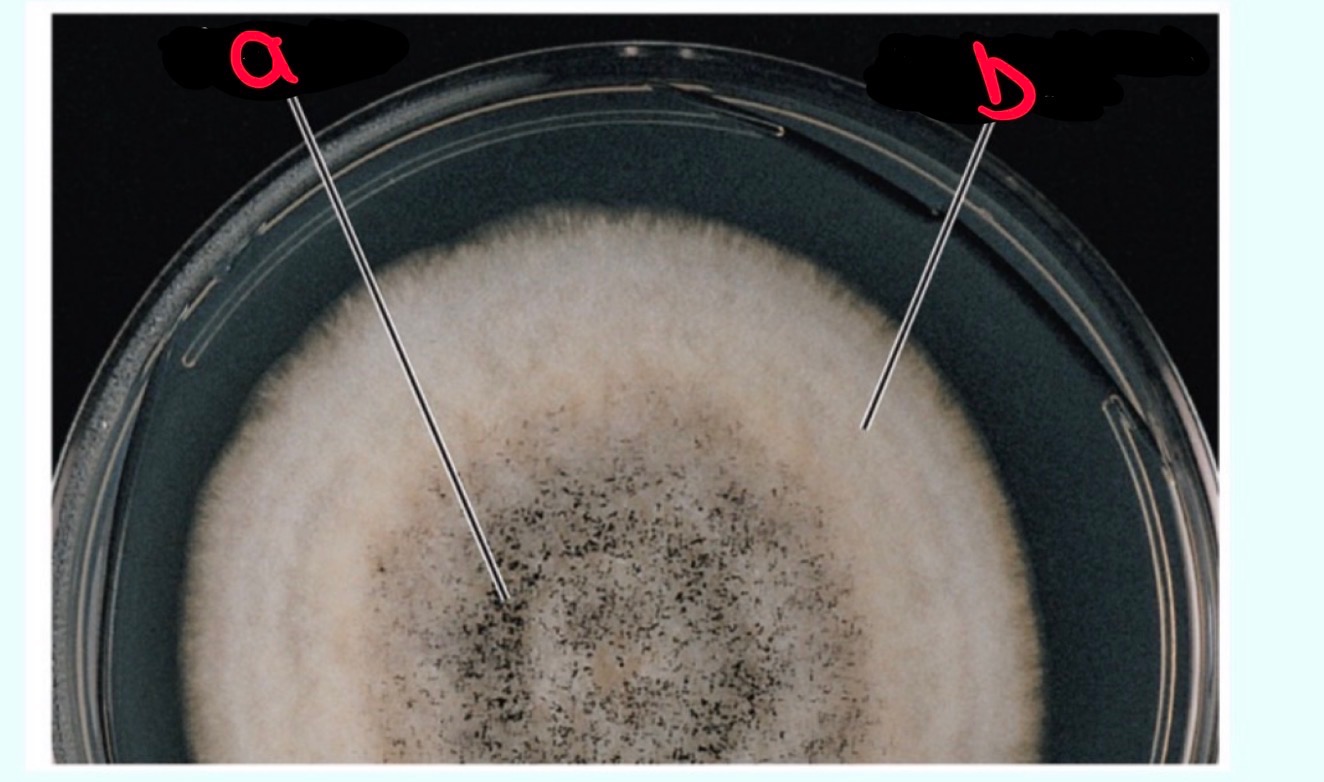
<p>Label this</p>
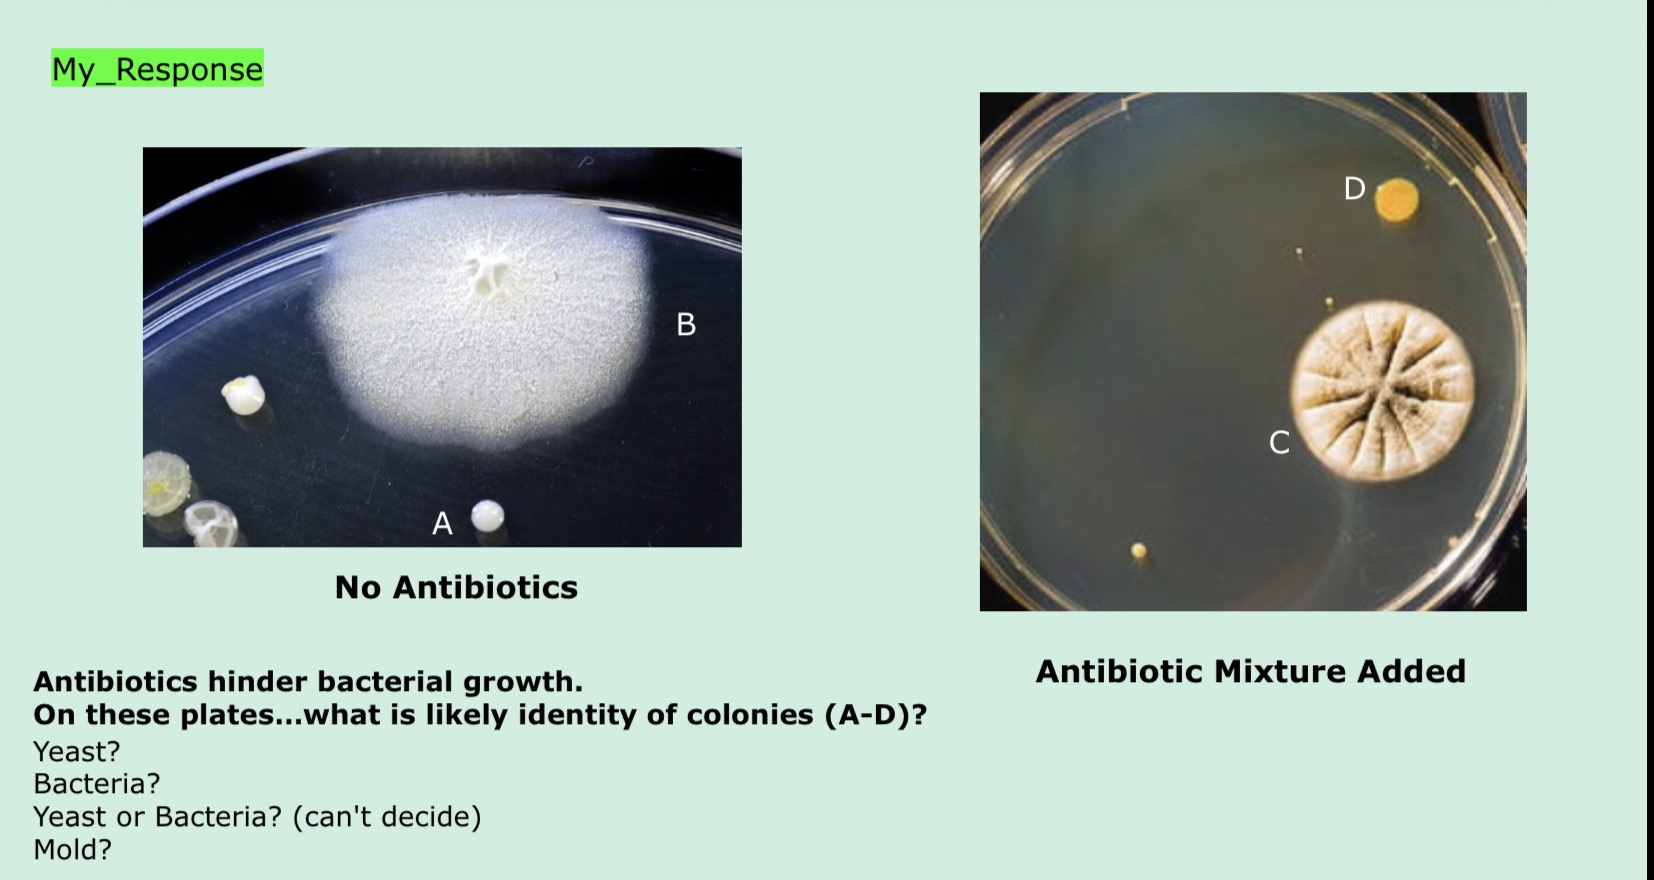
<p>Answer dis</p>

1/30
Looks like no tags are added yet.
Name | Mastery | Learn | Test | Matching | Spaced | Call with Kai |
|---|
No analytics yet
Send a link to your students to track their progress
Microbes of the Eukaryotic Realm
many eukaryotic microbes.
• 3 major groups we will focus on are:
• The Fungi
• The Microscopic Algae
• The Protozoa
Fungi
This group contains over 100,000 species!
• Many of which cause disease in humans, animals, and plants. • However, many species are also beneficial.
• Some of the key benefits of certain Fungi include:
• Their ability to decompose dead plants…meaning they can recycle elements
• The ability of some fungi (mycorrhizae) to form symbiotic relationships with plants and help absorb water and nutrients
• Their use in food production (e.g., ethanol from yeast) and antibiotic production
Mycology
The study of fungi is called Mycology.
• Members of this group are mainly chemoheterotrophs
• They decompose organic matter
• They are also mainly aerobic or facultative anaerobes
• They also have well known features that are different from bacteria
Fungi features that are different from bacteria:
Fungii Cell Wall: Glucans; mannans; chitin (no peptidoglycan)
Bacteria Cell Wall: Peptidoglycan
Fungi Spores: Sexual and asexual reproductive spores
Bacteria spores:Endospores (not for reproduction); some asexual reproductive spores
Many fungi are divided into 3 main categories:
Molds (grow via filaments) No mushrooms
Yeasts (unicellular)
Fleshy Fungi (grow via filaments mainly) (make mushrooms…highly visible fruiting bodies)
Characteristics of Fungi Vegetative Structures, With respect to molds and fleshy fungi:
The entire "body" of an individual is called the thallus
• Individual filaments are called hypha (plural = hyphae)
• When referring to hyphae together, they are called the mycelium.
• Also, along hypha for a given species, individual cells (with their nuclei) can either be o Divided into distinct cells, or o Remain as non-distinct cells
• If hyphae contain cross-walls (septa) between cells = septate hyphae
• If they do not contain septa between cells = aseptate hyphae

Label this
A) Septum
B) Septae hypha
C) Aseptae hypha (multinucleated)

What is this? label it
Fungal hypha, Growth of a hypha from a spore
a) spore b)Hypha c) hyphae d) mycellum

Label this
A) Septate hypha
b)Coenocytic hypha or aseptate hyphae
C) septum
d) Nuclei
e) pore
f) cell wall
Characteristics of Fungal Hyphae For molds and fleshy fungi: • As their hyphae grow, they will either be:
• Vegetative = meaning they are embedded in the substrate
• Aerial = meaning they have emerged into the air Why is this important?
• Generally, it is the vegetative hyphae that are obtaining nutrients
• While aerial hyphae are generally for reproduction
Label this
A)Aerial hyphae
B) Vegetative hyphae (mycellium)
Fungal Life Cycle For molds and fleshy fungi:
Their reproduction is based on the formation of spores that detach from the parent and germinate into a new mold or fleshy fungi.
• Spores can either be made sexually or asexually in fungi.
• Asexual spores = are those made via mitosis type cell divisions
• Individual spores go on to make new identical individuals
• Sexual spores = are those made via meiosis type cell divisions
• Spores make hyphae that can interact and share nuclei…these fuse to allow 'mating'….gives greater genetic variation
General Fungal Life Cycle…no mushroom, sexual reproduction
Dikaryotic Hyphae: fungal filaments a where each cell contains two genetically distinct, haploid nuclei from each parents.
Haploid (1n or n) unpaired chromosomes
Plasogamy: Haploid cells from two different mycelia fuse → Karyogamy: The nuclei fuse to form a diploid 2n zygote. (2n, paired chromosomes
Meiosis Haploid 1(n) spores are formed, 2n →
Germination: A multicellular mycelium is formed
Myceliium (1n)
Cycle repeats
General Fungal Life Cycle…no mushroom, asexual reproduction
A multicellular mycelium is formed through the other process
Myceliium (1n) → mitosis → spores → germination→ Myceliium (1n)
Fungal Spores
Additionally, fungal spores are also important for taxonomic identification:
Conidiospores = not enclosed in a sac
Arthroconidia spores = spores are fragmented septate hyphae
Blastoconidia spores = spores look like buds Yeast takes on 'pseudohypha' structure
Sporangiospores = enclosed in a sac

Label this
a)Conidiospores
b)sporagipsores inside a sporangium
C)Conidiospores
D)Arthroconidia spores
e)Blastoconidia spores
f)Sporangiospores
'fleshy' mushrooms
For some fungi they are known as 'fleshy' …meaning they create a "macro" structure that can be seen for spore dispersal…it is soft and squishy…hence 'fleshy'.
The fleshy fungi belong in mainly: Basidiomycota (Club fungi) = make a classic mushroom shape to disperse spores Ascomycota (Sac fungi) = make a 'mushroom' but spores remain in sac-like structures

Label this
A)Amanita (Basidiomycota)
B)Morchella (Ascomycota)
Woody" fungi
Hard, not squishy
General Fungal Life Cycle…with mushroom
Sexual: Mushroom- gill with basidia releases spores → Spore germination → hyphae →Hyphae meat (plasmogamy =first stage of sexual reproduction in fungi) with mycelium attached → mycelium form hyohal knot (reproductive growth) → Primordia (Early non-differentiated mushroom) → Mushroom
Asexual: Buds off cycle at hyphae → mycelium → hyphae
Characteristics of Yeast-like Fung
They are non-filamentous (no hyphae) and are unicellular Since they don't make septate or aseptate hyphae, they instead grow by:
• Budding = divide unevenly
• Fission = divide evenly
some fungi can also be yeast-like at 37°C and moldlike at 25°C = dimorphic fungi

What is this
First is budding
second is fission
then it is showing budding scars

What is this showing?
ome fungi can also be yeast-like at 37°C and moldlike at 25°C = dimorphic fungi
In terms of growing fungi in the lab:
Most molds are aerobic
• Most yeasts are facultative anaerobes
• Fungi can generally metabolize complex carbohydrates
Can grow on petri dishes
note center growth
Pathogenic Fungi
If you get a fungal infection this is called a mycosis.
Some notable pathogenic fungi are:
• Rhizopus stolonifer (common black bread mold)…pathogenic to many plants
• Rhizopus mucor…pathogenic to humans (causes premature tissue death)
You should also note that certain mushrooms are also toxic to human health if ingested…and some can lead to death.
• Amanita phalloides (death cap mushroom) As for pathogenic yeasts… Candida albicans is a major concern…infects various parts of the human body
Fungi and their Benefits
Some fungi also have positive uses to humans: Some notable taxa are:
• Saccharomyces cerevisiae: used in bread, wine, and hepatitis B vaccine production
• Lentinula edodes, Pleurotus ostreatus, & Grifola frondosa: shiitake, oyster, and maitake mushrooms
• Penicillium: used in antibiotic production and discovery. e.g penicillin and its derivatives
Microsporidia
This is an interesting group that is most closely related to fungi genetically…were once considered types of protists. Can lead to chronic diarrhea…it is an obligate intracellular parasite. Are mainly characterized by:
•The presence of a unique organelle: the polar tubule or polar filament
•Coiled inside and used to invade host cells

What is this?
the polar tubule or polar filament in Microsporidia
Used to invade digestive system cells, brain cells, sinuses, muscles, ect

What is this? label it and explain its life cycle when ingested
Microsporidia
A) mature spores b) Vacuole
spores are ingested or inhaled
Spore injects tube into host cell
cytoplasm and nucleus enter host cell
cytoplasm grows and nuclei reproduce
cytoplasm breaks up around nuclei to form spores
new spores are released
NOTE: The polar filament has an inside out orientation when it injects tube
ungal Colonies and Hyphae- how to identify
Ask if yeast like? If so will be on top of culture
Ask is hyphae/ mycelium? Then ask if aerial hyphae or vegetative hyphae
Answer dis
A) yeast or bacteria
B) Mold
c) mold
D) yeast